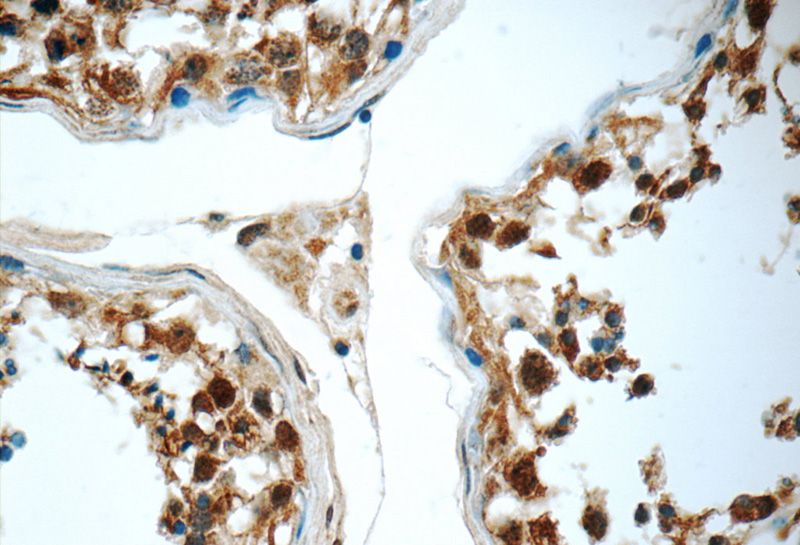
Immunohistochemistry of paraffin-embedded human testis tissue slide using Catalog No:111898(JTV1 Antibody) at dilution of 1:50 (under 40x lens)

-
Product Name
JTV1 antibody
- Documents
-
Description
JTV1 Rabbit Polyclonal antibody. Positive IHC detected in human testis tissue, human cerebellum tissue, human kidney tissue. Positive IF detected in Hela cells, HepG2 cells. Positive IP detected in HeLa cells. Positive WB detected in HeLa cells, HepG2 cells, K-562 cells, L02 cells, mouse liver tissue, NIH/3T3 cells, rat liver tissue. Observed molecular weight by Western-blot: 36 kDa
-
Tested applications
ELISA, WB, IF, IHC, IP
-
Species reactivity
Human,Mouse,Rat; other species not tested.
-
Alternative names
AIMP2 antibody; JTV1 antibody; JTV1 gene antibody; P38 antibody; PRO0992 antibody; Protein JTV 1 antibody
-
Isotype
Rabbit IgG
-
Preparation
This antibody was obtained by immunization of JTV1 recombinant protein (Accession Number: NM_006303). Purification method: Antigen affinity purified.
-
Clonality
Polyclonal
-
Formulation
PBS with 0.1% sodium azide and 50% glycerol pH 7.3.
-
Storage instructions
Store at -20℃. DO NOT ALIQUOT
-
Applications
Recommended Dilution:
WB: 1:200-1:2000
IP: 1:500-1:5000
IHC: 1:20-1:200
IF: 1:10-1:100
-
Validations

HeLa cells were subjected to SDS PAGE followed by western blot with Catalog No:111898(JTV1 antibody) at dilution of 1:1000

Immunofluorescent analysis of Hela cells, using JTV1 antibody Catalog No:111898 at 1:25 dilution and Rhodamine-labeled goat anti-rabbit IgG (red).

IP Result of anti-JTV1 (IP:Catalog No:111898, 3ug; Detection:Catalog No:111898 1:1000) with HeLa cells lysate 800ug.
Immunohistochemistry of paraffin-embedded human testis tissue slide using Catalog No:111898(JTV1 Antibody) at dilution of 1:50 (under 40x lens)
-
Background
JTV1, also named p38, AIMP2, was first knew as a factor associated with macromolecular protein complex, which consists several different aminoacyl-tRNA synthetases. JTV1 is a scaffold protein required for the assembly and stability of the multi-tRNA synthetase complex. JTV1 could act as a mediator of TGF-beta signaling and its functional importance in the control of MYC during lung differentiation. Blocks MDM2-mediated ubiquitination and degradation of p53/TP53. Functions as a proapoptotic factor. This is a rabbit polyclonal antibody raised against full-length of JTV1.
-
References
- Choo YS, Tang C, Zhang Z. Critical role of PINK1 in regulating Parkin protein levels in vivo. Archives of neurology. 68(5):684-5. 2011.
- Wong E, Bejarano E, Rakshit M. Molecular determinants of selective clearance of protein inclusions by autophagy. Nature communications. 3:1240. 2012.
- Gulati P, Cheung MK, Antrobus R. Role for the obesity-related FTO gene in the cellular sensing of amino acids. Proceedings of the National Academy of Sciences of the United States of America. 110(7):2557-62. 2013.
- Ma J, Chen M, Xia SK. Prostaglandin E2 promotes liver cancer cell growth by the upregulation of FUSE-binding protein 1 expression. International journal of oncology. 42(3):1093-104. 2013.
- Lee Y, Karuppagounder SS, Shin JH. Parthanatos mediates AIMP2-activated age-dependent dopaminergic neuronal loss. Nature neuroscience. 16(10):1392-400. 2013.
- Ko HS, Lee Y, Shin JH. Phosphorylation by the c-Abl protein tyrosine kinase inhibits parkin's ubiquitination and protective function. Proceedings of the National Academy of Sciences of the United States of America. 107(38):16691-6. 2010.
- Turanov AA, Shchedrina VA, Everley RA. Selenoprotein S is involved in maintenance and transport of multiprotein complexes. The Biochemical journal. 462(3):555-65. 2014.
- Jäger S, Cimermancic P, Gulbahce N. Global landscape of HIV-human protein complexes. Nature. 481(7381):365-70. 2012.
Related Products / Services
Please note: All products are "FOR RESEARCH USE ONLY AND ARE NOT INTENDED FOR DIAGNOSTIC OR THERAPEUTIC USE"
